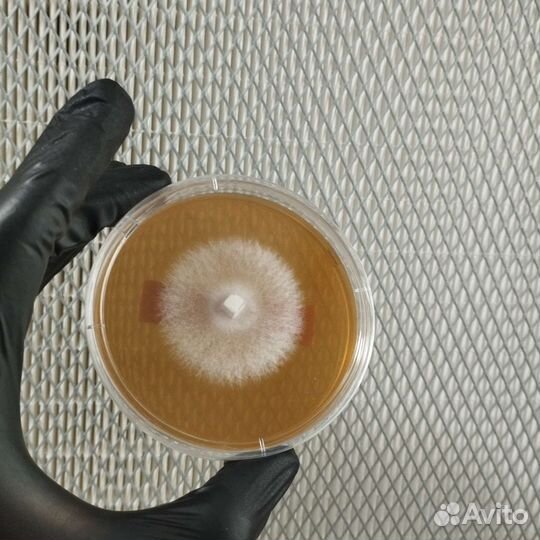
Мицелий

Кактус
150 руб.
Кактус молодой, при правильном уходе цветёт большими белыми цветами. Новый горшок, качественная земля.
Объвление найдено на сайте avito.ru. Перейдите по ссылке для покупки или просмотра более подробной информации